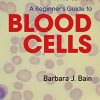
A Beginner’s Guide to Blood Cells, 3rd Edition (EPUB)

Big Mechanisms in Systems Biology: Big Data Mining, Network Modeling, and Genome-Wide Data Identification (PDF Book)
by Bor-Sen Chen (Author), Cheng-Wei Li (Author)
Big Mechanisms in Systems Biology: Big Data Mining, Network Modeling, and Genome-Wide Data Identification explains big mechanisms of systems biology by system identification and big data mining methods using models of biological systems. Systems biology is currently undergoing revolutionary changes in response to the integration of powerful technologies. Faced with a large volume of available literature, complicated mechanisms, small prior knowledge, few classes on the topics, and causal and mechanistic language, this is an ideal resource.
This book addresses system immunity, regulation, infection, aging, evolution, and carcinogenesis, which are complicated biological systems with inconsistent findings in existing resources. These inconsistencies may reflect the underlying biology time-varying systems and signal transduction events that are often context-dependent, which raises a significant problem for mechanistic modeling since it is not clear which genes/proteins to include in models or experimental measurements.
The book is a valuable resource for bioinformaticians and members of several areas of the biomedical field who are interested in an in-depth understanding on how to process and apply great amounts of biological data to improve research.
- Written in a didactic manner in order to explain how to investigate Big Mechanisms by big data mining and system identification
- Provides more than 140 diagrams to illustrate Big Mechanism in systems biology
- Presents worked examples in each chapter
Product Details
- eBook Digital: 878 pages
- Publisher: Academic Press; 1 edition (November 25, 2016)
- Language: English
- ISBN-10: 0128094796
- ISBN-13: 978-0128094792